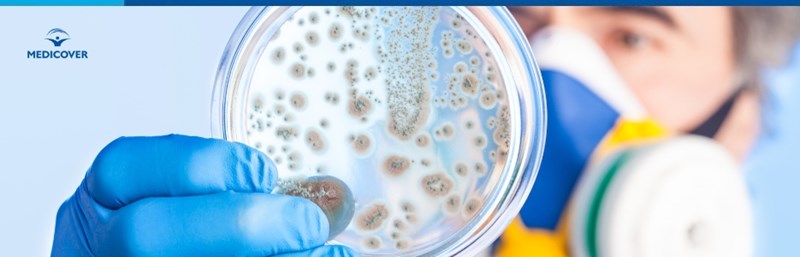

Impetigo este o epidermita contagioasa a carei evolutie presupune aparitia de vezicule/bule care prin rupere genereaza aparitia de cruste melicerice galbene - maronii, asemanatoare cu mierea, de unde si denumirea populara de „bube dulci”.
Formele usoare de impetigo prezinta evolutie autolimitata si se remit spontan in majoritatea cazurilor. Exista insa si situatii in care patologia se poate complica prin diseminarea infectiei streptococice (unul dintre agentii etiologici ai bubelor dulci) care determina aparitia glomerulonefritei acute poststreptococice sau a scarlatinei.
Tratamentul formelor complicate de impetigo beneficiaza de tratament antibiotic oral sau injectabil cu antibioterapice, in conformitate cu severitatea complicatiilor secundare si sensibilitatea germenului patogen implicat in aparitia acestora.
Cuprins
- Ce este boala impetigo?
- Cauze bube dulci
- Tipuri de bube dulci
- Cum se transmit bubele dulci?
- Factori de risc impetigo
- Tratament bube dulci adulti si copii
- Complicatii impetigo
- Cum putem sa prevenim transmiterea bolii impetigo?
Sumar: - Impetigo este o infectie contagioasa care afecteaza de obicei copiii. |
Ce este boala impetigo?
Impetigo reprezinta o boala infecto-contagioasa determinata de catre streptococul beta hemolitic de grup A si stafilococul auriu. Impetigo de etiologie streptococica este mai frecvent intalnit la copii din tarile cu climat tropical, insa patologia prezinta incidenta crescuta si in restul zonelor geografice, afectand uneori si populatia adulta.
Impetigo este o boala foarte contagioasa manifestata sub forma unei eruptii tegumentare veziculoase sau buloase. Aceasta evolueaza spontan catre rupere cu formarea de cruste melicerice cu aspect caracteristic de miere. Eruptia se manifesta la nivel perioral si/sau perinazal si poate asocia in anumite situatii disconfort algic local sau senzatie de mancarime si arsura.
Pruritul poate genera scarpinat excesiv si favorizeaza raspandirea patogenului bacterian in alte zone ale corpului prin autoinoculare.
In etapa de vindecare, crustele se remit si dupa desprindere genereaza aparitia discoloratiilor tegumentare (piele hipopigmentata sau hiperpigmentata) care se estompeaza odata cu trecerea timpului.
Evolutia bubelor dulci de la debutul eruptiei veziculoase pana la desprinderea crustelor este de maxim 30 de zile in lipsa tratamentului antibiotic si de aproximativ 7 zile la persoanele care au beneficiat de antibioterapice.
In cazuri rare, impetigo poate evolua cu adenopatii locale (inflamarea ganglionilor limfatici laterocervicali, submandibulari) sindrom febril, stare generala de slabiciune, inapetenta sau manifestari digestive de tipul scaunelor diareice.
Cauze bube dulci
Impetigo (bube dulci) determinat de Staphylococcus aureus apare mai frecvent pe timpul verii in cazul copiilor cu varsta cuprinsa intre 2 si 5 ani.
Stafilococul auriu reprezinta un germen care se regaseste in mod fiziologic la suprafata tegumentelor si poate coloniza mucoasa nazala la purtatorii asimptomatici.
Stafilococul auriu poate fi raspandit cu usurinta de la o persoana la alta prin contact direct al tegumentelor, insa nu dezvolta infectii decat in cazul in care exista o solutie de continuitate la nivelul pielii. Solutiile de continuitate ale pielii reprezinta leziuni care pot aparea in urma unei intepaturi de insecta, iritatii ale pielii sau afectiuni dermatologice cronice.
Streptococul beta hemolitic de grup A constituie cea de-a doua cauza implicata in aparitia „bubelor dulci”, acest patogen fiind regasit la suprafata pielii si la nivelul mucoasei faringiene.
In anumite conditii favorizante, streptococul pyogenes poate determina patologii ale pielii de tipul impetigo-ului, iar in cazuri severe, bacteria prezinta capacitate de diseminare prin torentul sangvin, generand febra reumatica, afectare cardiaca sau glomerulonefrita acuta.
Tipuri de bube dulci
- Impetigo nonbulos sau forma contagioasa a bubelor dulci poate fi generat atat de Staphylococcus aureus, cat si de S.pyogenes in anumite situatii, putand fi prezenta o coinfectie cu cei 2 germeni. Impetigo nonbulos implica aparitia leziunilor veziculoase cu tendinta de spargere, in urma carora apar cruste melicere specifice.
- Impetigo bulos este determinat exclusiv de catre aureus. Leziunile acestei forme de boala fiind datorate actiunii toxinei stafilococice asupra pielii, ce determina aparitia de bule (basici cu lichid care nu prezinta tendinta de rupere spontana) cu aspect sero citrin (galben deschis). Sugarii si copii cu varsta de pana la 2 ani sunt cei mai afectati de aceasta forma de impetigo, eruptia buloasa putand avea localizare periorala, la nivelul membrelor sau trunchiului.
Cum se transmit bubele dulci?
Transmiterea agentilor bacterieni responsabili de aparitia impetigo-ului se poate produce prin contact direct cu leziunile bolnavului, utilizarea in comun a hainelor, lenjeriei si prosoapelor cu o persoana infectata in conditiile existentei unei solutii de continuitate la nivel tegumentar (taieturi, intepaturi, iritatii, leziuni de grataj).

Factori de risc impetigo
Principalii factori care favorizeaza aparitia „bubelor dulci” sunt reprezentati de:
- Muscaturi de insecte
- Infestare cu parazitul Sarcoptes scabiei
- Iritatii ale pielii (dupa barbierit, cauzate de scutec sau proceduri cosmetice dermo abrazive)
- Tinea
- Dermatita cronica
- Varicela.
Majoritatea acestor factori favorizeaza aparitia pruritului, scarpinatul excesiv, ceea ce determina constituirea de microleziuni la suprafata pielii, prin care se pot propaga agentii etiologici ai „bubelor dulci”.
Aglomeratiile populationale, caldura si umiditatea excesiva, reprezinta principalii factori de mediu care favorizeaza raspandirea impetigoului cauzat de S.pyogenes si S.aureus.
Diabetul zaharat, deficitul imun, infectia cu Herpes simplex si afectiunile respiratorii care evolueaza cu rinoree si asociaza iritatii in jurul nasului si a cavitatii bucale prin utilizarea frecventa a servetelelor constituie alti factori de risc care predispun la aparitia infectiilor pielii cauzate de stafilococul auriu si streptococul beta hemolitic de grup A.
Tratament bube dulci adulti si copii
Tratamentul impetigo este etiologic si are ca scop eradicarea germenilor microbieni implicati in aparitia leziunilor tegumentare inalt contagioase. Terapia antibiotica scurteaza durata de evolutie a leziunilor si favorizeaza procesele de vindecare la nivel tisular, prevenind in acelasi timp diseminarea bacteriilor in torentul sangvin si totodata riscul de aparitie al complicatiilor secundare.
Managementul medicamentos al impetigo-ului cuprinde antibioterapice cu aplicare locala (creme, unguente) si cu administrare sistemica, recomandate de catre medicul curant in conformitate cu susceptibilitatea la antibiotice a agentilor etiologici.
Pe durata evolutiei bolii, pacientul este incurajat sa mentina o igiena corporala riguroasa si sa evite scarpinatul pentru a diminua riscul de autoinoculare al bacteriilor. La nivel lezional local se mai pot aplica topice cu rol antiseptic si cicatrizant dupa igienizarea corespunzatoare a tegumentului.
Complicatii impetigo
Evolutia complicata a impetigo-ului se datoreaza extinderii infectiei bacteriene la nivelul organismului care se poate manifesta sub forma:
- Glomerulonefritei poststreptococice - afectarea renala este provocata de formarea de complexe imune specifice, care determina inflamatia glomerulara cu scaderea functionalitatii acestora.
- Fasceita necrozanta datorata patrunderii pyogenes in profunzimea tegumentului.
- Sindromul socului toxic datorat toxinelor bacteriene eliberate de catre patogeni in circulatia sangvina.
- Febra reumatica o patologie de tip autoimun intalnita mai frecvent la copii cu varsta intre 2 si 5 ani cu manifestare la nivel cardiac, articular si cerebral.
- Celulita infectioasa - patologie determinata de infectia bacteriana a tesutului subepidermal.
- Limfangita manifestata prin edem din cauza diseminarii pe cale limfatica a bacteriilor.
Cum putem sa prevenim transmiterea bolii impetigo?
Principalele masuri aplicate cu succes pentru a preveni raspandirea bubelor dulci sunt reprezentate de:
- Igienizarea regulata a leziunilor cu apa calda si sapun.
- Dezinfectarea periodica a mainilor si a leziunilor tegumentare cu solutii antiseptice si aplicarea locala de creme antiseptice.
- Protejarea leziunilor prin bandaj ocluziv steril.
- Evitarea scarpinatului care favorizeaza raspandirea bacteriilor.
- Izolarea pe cat posibil a bolnavului pana la desprinderea crustelor sau in primele 48 de ore de la initierea tratamentului antibiotic.
- Igienizarea corespunzatoare a lenjeriei si obiectelor vestimentare ale bolnavului prin spalare la temperatura cat mai inalta.
- Igienizarea suprafetelor atinse de catre persoana infectata.
- Evitarea piscinelor, saunelor si a spa-urilor in primele zile dupa initierea tratamentului antibiotic sau pana la vindecarea leziunilor pentru persoanele care nu au optat pentru terapie medicamentoasa.
Referinte:
- Impetigo, Nardi NM , Schaefer TJ, Europe PMC
- Impetigo Contagiosa. The Association of Certain Types of Staphylococcus Aureus and of Streptococcus Pyogenes with Superficial Skin Infections, M. T. Parker, A. J. H. Tomlinson, R. E. O. Williams, Cambridge University Press:
- Impetigo: Diagnosis and Treatment, American Family Physician
- Interventions for impetigo
Intrebari Frecvente (FAQ)
Cum se transmit bubele dulci?
Transmisia impetigo se face prin contact direct cu leziunile unei persoane infectate sau prin utilizarea comuna a hainelor si prosoapelor, in special in cazul unor leziuni ale pielii.
Cum pot sti daca am impetigo?
Eruptiile specifice se manifesta sub forma de vezicule care ulterior se rup, formand cruste melicerice, si pot fi insotite de prurit si disconfort al pielii.
Care este tratamentul pentru impetigo?
Tratamentul implica antibioterapice aplicate local sau sistemic, in functie de severitatea infectiei, si include masuri de igiena pentru a preveni raspandirea bacteriilor.
Cine risca sa dezvolte impetigo?
Impetigo afecteaza in special copii cu varste intre 2 si 5 ani, dar poate aparea si la adulti, in special in zone cu aglomerari populationale si conditii de mediu favorabile.